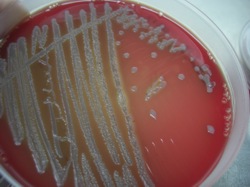

| Bacillus pumilus |
| Hemolytic colonies of B. pumilus ( 72h incubation) |
| Bacillus pumilus vegetative cells and spores |
| Bacillus pumilus colonies on Sheep Blood Agar after 24h incubation |
Taxonomy
Morphology
Cultural characteristics
Biochemical characters
Ecology
Pathogenicity
References
Phylum Bacillota (Firmicutes), Class Bacilli, Order Caryophanales, Family Bacillaceae, Genus Bacillus, Bacillus pumilus Meyer and
Gottheil (1901).
Possible old synonym: Bacillus mesentericus Trevisan.
Gottheil (1901).
Possible old synonym: Bacillus mesentericus Trevisan.
Gram-positive or Gram-variable, 2.0-3.0 x 0.6-0.7 μm, motile rods with peritrichous
flagella. Ellipsoidal or cylindrical, central, paracentral or subterminal spore, not
deforming the vegetative cell. Capsule is not present.
flagella. Ellipsoidal or cylindrical, central, paracentral or subterminal spore, not
deforming the vegetative cell. Capsule is not present.
Colonial morphology is variable; colonies may be wrinkled and irregular, and they are
unpigmented and most are opaque. The colonies of most strains on nutrient agar are
smooth and become slightly yellowish (and brown when aged - admin note).
Nonhemolytic on sheep blood agar, although 3 hemolitic strains biochemically
identified as Bacillus pumilus both by 'API CHB + API 20E' and 'ABIS online' were
isolated from sheep milk, honey and contaminated medium (admin note). Aerobic,
does not grow anaerobically. Growth at pH 5.7-9.5, some strains will grow at pH 4.5.
Grow in 0-10% NaCl. Temperature range: 5-15 ºC to 40-50 ºC. Allantoin or urate are
not required for growth.
unpigmented and most are opaque. The colonies of most strains on nutrient agar are
smooth and become slightly yellowish (and brown when aged - admin note).
Nonhemolytic on sheep blood agar, although 3 hemolitic strains biochemically
identified as Bacillus pumilus both by 'API CHB + API 20E' and 'ABIS online' were
isolated from sheep milk, honey and contaminated medium (admin note). Aerobic,
does not grow anaerobically. Growth at pH 5.7-9.5, some strains will grow at pH 4.5.
Grow in 0-10% NaCl. Temperature range: 5-15 ºC to 40-50 ºC. Allantoin or urate are
not required for growth.
Widely distributed in clinical (human faeces and ileum) and veterinary specimens,
food ingredients, emperor moth caterpillars, leather, paper. Spores are widely
distributed in nature (soil, plants).
Variable growth in the presence of lysozyme.
Isolates of Bacillus pumilus from Antarctic soils and penguin rookeries show some
phenotypic distinction from other strains of the species, including the production of a
diffusible yellow pigment by some strains on initial culture.
food ingredients, emperor moth caterpillars, leather, paper. Spores are widely
distributed in nature (soil, plants).
Variable growth in the presence of lysozyme.
Isolates of Bacillus pumilus from Antarctic soils and penguin rookeries show some
phenotypic distinction from other strains of the species, including the production of a
diffusible yellow pigment by some strains on initial culture.
Food intoxications to humans: may produce toxins - a complex of lipopeptides
(pumiciladines). Rarely encountered. May be involved in rectal fistula.
Isolated from bovines with mastitis (rarely).
Caused widespread lysis and damage (including nuclear condensation and
fragmentation , cell lysis and necrosis, vacuolation and apoptosis) to HEp-2 cells.
Antifungal activity; used in agriculture.
(pumiciladines). Rarely encountered. May be involved in rectal fistula.
Isolated from bovines with mastitis (rarely).
Caused widespread lysis and damage (including nuclear condensation and
fragmentation , cell lysis and necrosis, vacuolation and apoptosis) to HEp-2 cells.
Antifungal activity; used in agriculture.
- Bîlbîie V., Pozsgi N., 1985, Bacteriologie Medicală, vol.ll, Ed. Medicală, Bucureşti.
- Gordon R.E., Haynes W.C., Pang C.H. (1973) – The genus Bacillus. Agriculture Handbook No. 427, U.S.D.A., Washington D.C.
- Buchanan R.E., Gibbons N.E., Cowan S.T., Holt J.G., Liston J., Murray R.G.E., Niven C.F., Ravin A.W., Stanier R.W. ( 1974) –
Bergey’s Manual of Determinative Bacteriology, Eight Edition, The Williams & Wilkins Company, Baltimore. - Bottone, Edward J; Peluso, Richard W: Production by Bacillus pumilus (MSH) of an antifungal compound that is active against
Mucoraceae and Aspergillus species: preliminary report. Journal of Medical Microbiology. 52(1):69-74, January 2003. - Buiuc D., Negut M. , 1999. Tratat de Microbiologie Clinica, Editura Medicala, Bucuresti.
- N.A. Logan and P. De Vos, 2009. Genus I. Bacillus Cohn 1872. In: (Eds.) P.D. Vos, G. Garrity, D. Jones, N.R. Krieg, W. Ludwig, F.A.
Rainey, K.-H. Schleifer, W.B. Whitman. Bergey’s Manual of Systematic Bacteriology, Volume 3: The Firmicutes, Springer, 21-127. - Hoyles L., Honda H., Logan N.A., Halket G., La Ragione R., McCartney A.L., 2012. Recognition of greater diversity of Bacillus
species and related bacteria in human faeces. Research in Microbiology 163, 3-13. - Liu Y, Lai Q, Du J, Shao Z. Bacillus zhangzhouensis sp. nov. and Bacillus australimaris sp. nov. Int J Syst Evol Microbiol 2016; 66:
1193-1199.
Positive results for alkaline phosphatase, acid phosphatase, esterase (C4), esterase
lipase (C8), naphthol-AS-BIphosphoamidase, beta-glucosidase, beta-galactosidase,
Voges-Proskauer test, citrate utilization, hydrolysis of esculin, hydrolysis of gelatin,
hydrolysis of casein, acid production from: N-acetyl-D-glucosamine, L-arabinose,
amygdalin, arbutin, D-cellobiose, D-fructose, galactose, glucose, glycerol,
beta-gentibiose, D-mannose, D-raffinose, ribose, sucrose, salicin, trehalose and
D-xylose.
Negative results for trypsin, alpha-glucosidase, cystine aminopeptidase,
alpha-galactosidase, reduction of nitrate to nitrite, starch hydrolysis, indole, hippurate,
arginine dihydrolase, lysine decarboxylase, ornithine decarboxylase, tryptophan
deaminase, egg yolk reaction, phenylalanine deaminatetion, degradation of tyrosine,
acid production from: D-arabinose, adonitol, D- or L-arabitol, glycogen, methyl
beta-xyloside, starch, dulcitol, erythritol, D- or L-fucose, inulin, 2- or 5-ketogluconate,
gluconate, lyxose, D-melezitose, rhamnose, sorbose, xylitol and L-xylose.
Variable results for oxidase, acid production from: meso-inositol, lactose, maltose,
D-melibiose and sorbitol.
lipase (C8), naphthol-AS-BIphosphoamidase, beta-glucosidase, beta-galactosidase,
Voges-Proskauer test, citrate utilization, hydrolysis of esculin, hydrolysis of gelatin,
hydrolysis of casein, acid production from: N-acetyl-D-glucosamine, L-arabinose,
amygdalin, arbutin, D-cellobiose, D-fructose, galactose, glucose, glycerol,
beta-gentibiose, D-mannose, D-raffinose, ribose, sucrose, salicin, trehalose and
D-xylose.
Negative results for trypsin, alpha-glucosidase, cystine aminopeptidase,
alpha-galactosidase, reduction of nitrate to nitrite, starch hydrolysis, indole, hippurate,
arginine dihydrolase, lysine decarboxylase, ornithine decarboxylase, tryptophan
deaminase, egg yolk reaction, phenylalanine deaminatetion, degradation of tyrosine,
acid production from: D-arabinose, adonitol, D- or L-arabitol, glycogen, methyl
beta-xyloside, starch, dulcitol, erythritol, D- or L-fucose, inulin, 2- or 5-ketogluconate,
gluconate, lyxose, D-melezitose, rhamnose, sorbose, xylitol and L-xylose.
Variable results for oxidase, acid production from: meso-inositol, lactose, maltose,
D-melibiose and sorbitol.

(c) Costin Stoica

| Antibiogram |
| Encyclopedia |
| Culture media |
| Biochemical tests |
| Stainings |
| Images |
| Movies |
| Articles |
| Identification |
| Software |
| R E G N U M PROKARYOTAE |

| Back |